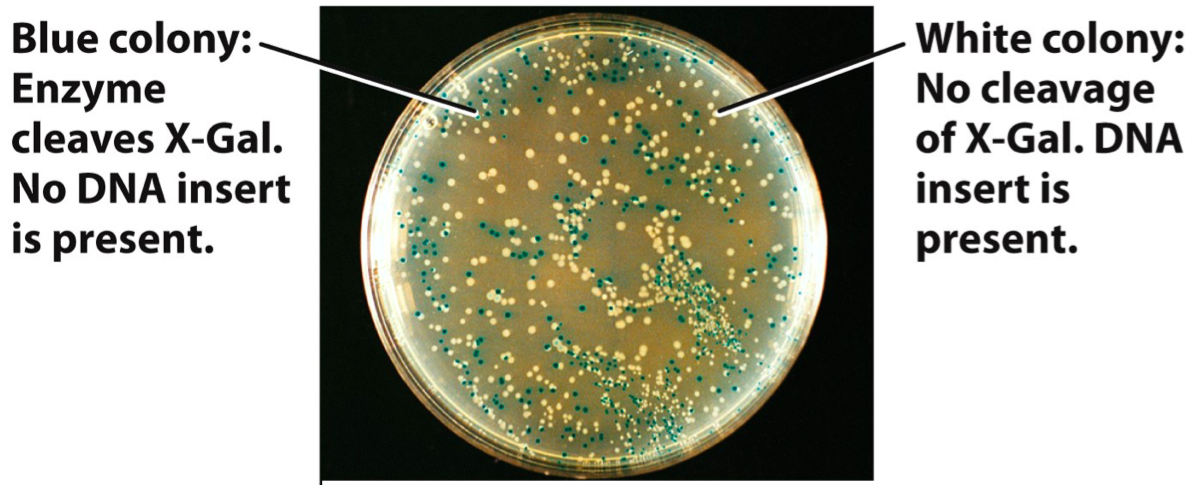

What two criteria must the mechanisms of gene expression fulfill?
What is the control of gene expression primarily governed by?
The control of gene expression is governed primarily by DNA-binding proteins that recognize specific control sequences of genes. (shown: the binding of the Lac repressor protein to the lac operator DNA)

What controls transcription of a gene?
Regulatory proteins
Binding sites for repressors in bacteria are called ________.
operators
operator
In bacteria, operators are binding sites for repressor regulatory proteins
promoter
The DNA sequence that participates in the DNA-protein interaction that determines where\ transcription begins
activator
Activators are regulatory proteins that function by binding sequence-specifically to a DNA site located in or near a promoter and making protein–protein interactions with the general transcription machinery (RNA polymerase and general transcription factors), thereby facilitating the binding of the general transcription machinery to the promoter. The DNA site bound by the activator is referred to as an “activator site.” The part of the activator that makes protein–protein interactions with the general transcription machinery is referred to as an “activating region.” The part of the general transcription machinery that makes protein–protein interactions with the activator is referred to as an “activation target.”
repressor
A DNA-binding repressor is a regulatory protein that blocks the attachment of RNA polymerase to the promoter, thus preventing transcription of the genes into messenger RNA. An RNA-binding repressor binds to the mRNA and prevents translation of the mRNA into protein. This blocking of expression is called repression.
Define positive regulation of a gene
In positive regulation, an activator protein must bind to its target DNA site as a necessary prerequisite for transcription to begin

Define negative regulation of a gene
In negative regulation, a repressor protein must be prevented from binding to its target site as a necessary prerequisite for transcription to begin

genetic switch
Genetic switches control gene transcription. The on/off function of the switches depends on the interactions of several proteins with their binding sites on DNA. RNA polymerase interacts with the promoter to begin transcription. Activator or repressor proteins bind to sites in the vicinity of the promoter to control its accessibility to RNA polymerase.
allosteric effector
Allosteric effectors control the ability of activator or repressor proteins to bind to their DNA target sites

Describe an allosteric activator
Some activator or repressor proteins must bind to their allosteric effectors before they can bind DNA

Describe an allosteric repressor
Some activator or repressor proteins bind DNA only in the absence of their allosteric effectors

What must activators and repressors be capable of in order to function?
Both activator and repressor proteins must be able to recognize when environmental conditions are appropriate for their actions and act accordingly. Thus, for activator or repressor proteins to do their job, each must be able to exist in two states: one that can bind its DNA targets and another that cannot.
X-Gal
X-gal (also abbreviated BCIG for 5-bromo-4-chloro-3-indolyl-β-D-galactopyranoside) is an organic compound consisting of galactose linked to a substituted indole. X-gal is an analog of lactose, and therefore may be hydrolyzed by the β-galactosidase enzyme which cleaves the β-glycosidic bond in D-lactose. X-gal, when cleaved by β-galactosidase, yields galactose and 5-bromo-4-chloro-3-hydroxyindole. The latter then spontaneously dimerizes and is oxidized into 5,5’-dibromo-4,4’-dichloro-indigo, an intensely blue product which is insoluble. X-gal itself is colorless, so the presence of blue-colored product may therefore be used as a test for the presence of active β-galactosidase. This easy identification of an active enzyme allows the gene for β-galactosidase (the lacZ gene) to be used as a reporter gene in various applications.

Blue-White screening
DNA inserts disrupt a gene (lacZ) in the plasmid that encodes an enzyme (β-galactosidase) necessary to cleave a compound added to the agar (X-gal) so that it produces a blue pigment. Thus, the colonies that contain the plasmids with the DNA insert will be white rather than blue (they cannot cleave X-gal because they do not produce β-galactosidase).
lactose
Lactose is a disaccharide sugar derived from galactose and glucose

DNA-binding domain (regulatory protein)
The site on a regulatory protein that binds DNA

allosteric site (regulatory protein)
The allosteric site, acts as a sensor that sets the DNA-binding domain in one of two modes: functional or nonfunctional. The allosteric site interacts with small molecules called allosteric effectors


Where does a prokaryotic activator bind?
The activator-binding site

Where does a prokaryotic repressor bind?
At the operator

positive regulation
An activator binds at the activator-binding site and transcription begins